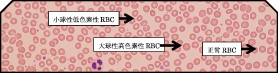
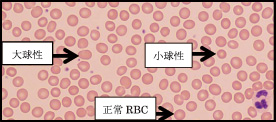

ビタミンB12欠乏との関連
| 東区・郡元支部 (デイジークリニック) 武元 良整 |
|---|
中学生から高校生の時期は成長期のため,または部活など多忙にて栄養的に偏りやすい時期です。朝礼などで倒れ,低血圧を認めると医学的には「起立性低血圧症」と考えられます。その際に鑑別すべきは「潜在性の鉄欠乏状態:かくれ貧血」や成長期に伴う「ビタミンB12欠乏」などの病態があります。貧血様の症状や不定愁訴のため毎朝,起床困難にて不登校となる場合もあります1)。起立性低血圧・倦怠感の主訴で来院した2症例を呈示いたします。
症 例 1 :17歳,高校2年生,女性
主 訴 :1カ月前から貧血気味。症状は以下のように多彩。「倦怠感」「立ちくらみ」「顔面蒼白」「アザできやすい」「便秘や下痢」「頭痛」「朝,起床困難」。
背 景:生卵による蕁麻疹などアレルギー歴あり。その他には食事の好き嫌いなし。部活動はテニス部所属だが,これまで貧血症状は自覚せず。
病 歴:上記主訴にて来院。近医へ貧血傾向を訴えて受診。起立性低血圧の診断を受け以下の投薬で治療中。「メトリジン」など,複数の内服継続後も症状は改善せず。その後肝機能悪化,胆のう炎の診断のもと,複数の消化器薬を内服中。貧血精査目的で来院。
理学所見:身長155.7cm,体重45.3kg,眼瞼結膜に貧血なく,黄疸も認めない。
漢方問診:疲れやすく日中に眠気がある(気虚),体が重い,たちくらみあり,車に酔いやすい(水滞),生理痛,こむらがえりもある。皮膚がカサカサしている。眠れない(血虚)。
漢方腹証:両臍傍痛あり,右優位。
末梢血検査:CBC(complete blood count)は貧血なし。
| 検査結果 |
| RBC:441万/μL,Hb:13.4g/dL,MCV (mean corpuscular volume:平均赤血球容積):89.3f L,MCH(mean corpuscular hemoglobin:平均赤血球血色素値):30.4pg,PLT(血小板数):27.2万/μL |
|
| 図 1 末梢血液像:RBC形態はほぼ正球性正色素性だが,大小不同を軽度に認める。 (末梢血液画像は鹿児島市医師会臨床検査センター血液検査室へ依頼し撮影いただきました) |
血液生化学検査:血清フェリチン値はやや高値(86.6ng/mL),小球性低色素性RBCを血液標本上に10%程度認める。血清ビタミンB12値は273pg/mL(基準値180-914)と低値,葉酸値は7.8ng/mL(基準値4以上)。鉄欠乏状態を示唆する小球性低色素性の末梢血液画像だが,低フェリチンではないため,肝機能障害によるフェリチン増加などを疑い血液生化学検査を追加し,肝機能の上昇を認めた(γ-GTP=50,AST=46,ALT=78)。薬剤性の可能性もあり,それまでの内服薬は中止した。なお,1カ月後,肝機能はすべて正常化した。
治 療:ビタミンB12は273pg/mLにて低値と判断。したがって,治療はビタミンB12静注で開始した。葉酸も造血亢進にともなう消耗が見込まれるため1カ月間内服とした。当帰芍薬散内服は高度の生理痛,こむらがえりがあるため,内服開始。
最終診断:1. 広義のかくれ貧血(ビタミンB12低値,末梢血標本には小球性低色素性RBCを認め潜在性の鉄欠乏状態と診断),2. 肝機能障害による高フェリチンの疑い。
症 例 2 :17歳,高校2年生,女性
主 訴 :4年前から朝がきつくて起きられない,欠席が多くて留年の可能性あり。冷え,肩こり,頭痛。
現 病 歴:中学1年生から①起立性低血圧で漢方内服。高校1年生から心療内科で,②自律神経失調と診断され,カウンセリングを受ける。低血圧に「メトリジン」を内服するも,治療効果がないため,かくれ貧血等を家族が疑い来院。
背 景:テニス部。全国大会出場予定。
理学所見:身長161cm,体重60.3kg,眼瞼結膜に貧血なく,黄疸も認めない。
漢方問診:疲労感あり,体が重く,たちくらみや手のこわばりあり(気虚+水滞),生理痛高度で便秘傾向(■血),天候悪化で頭痛あり。
腹 証 :胸脇苦満と両臍傍痛あり,右優位。
末梢血検査:CBCではHb:14.5と正常
| 検査結果 |
| RBC:471万/μL,Hb:14.5g/dL,MCV:90.9f L,MCH:30.8pg,PLT:20.1万/μL |
|
| 図 2 末梢血液像:RBC形態は大小不同1+あり,多染性1+。 (末梢血液画像は鹿児島市医師会臨床検査センター血液検査室へ依頼し撮影いただきました) |
血液生化学検査:血清フェリチン値は32.5ng/mL,血清ビタミンB12値は307pg/mL(基準値180-914)と両者とも軽度低値,葉酸値は6.3ng/mL(基準値4以上)。
臨床経過:症例1と同様に広義のかくれ貧血と診断した2)。治療は鉄剤+ビタミンB12静注で開始したところ,治療翌日は登校できたとの事。■血,血虚にて漢方内服(当帰芍薬散+桂枝茯苓丸)を併用した。33日間で静注終了し,現在はほぼ毎日登校。1カ月後は県外でのテニス大会出場予定。生理痛は漢方(桂枝茯苓丸のみ)で軽減中。
最終診断:1. 広義のかくれ貧血(鉄欠乏状態軽度,ビタミンB12低値),2. 月経前症候群
まとめ:2症例ともに倦怠感軽減し,朝の起床困難改善し登校可能となりました。共通するのは1.「起立性低血圧症」,2. 血色素レベルでは貧血を認めず,かくれ貧血,3. 月経前症候群を認める,以上の点です。症状の改善には「かくれ貧血」と考え,鉄よりもビタミンB12の補充が有効でした。ビタミンB12はその検査値に注目し500以下であれば,補充する事が症状改善に有用でした2)。
ただし,17歳という感受性の強い時期のため,常に精神的な支持と女性にとって避けては通れない月経前症候群への配慮も必要です。
文 献
1. 山本佳奈:貧血大国・日本 放置されてきた国民病の原因と対策. 光文社新書,2016年4月初版
2. 武元良整:かくれ貧血:Silent Anemia.鹿児島市医報第56巻第1号(通巻659号):46-47,2017
(C)Kagoshima City Medical Association 2017